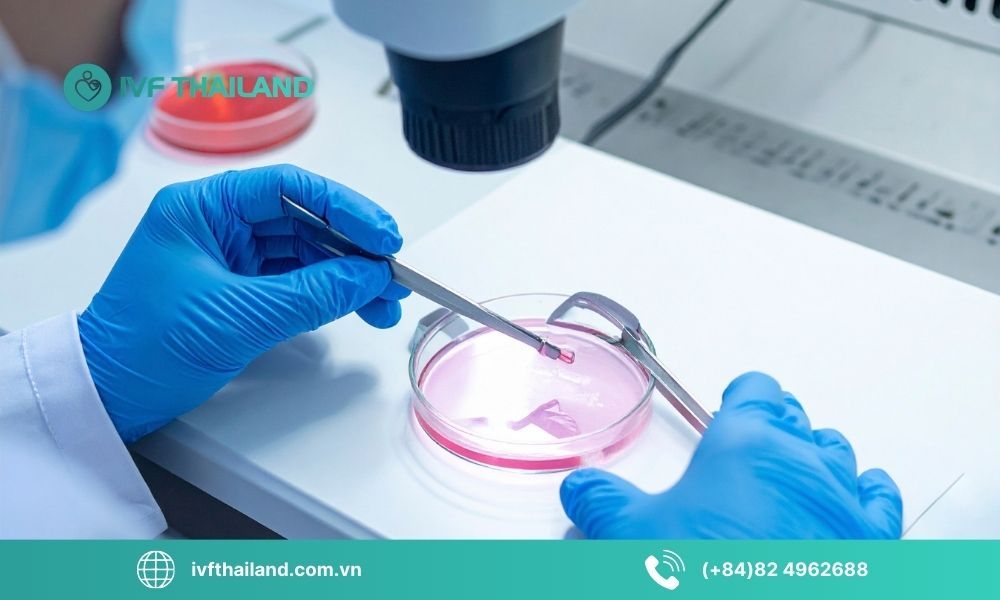
Chất lượng trứng là gì?
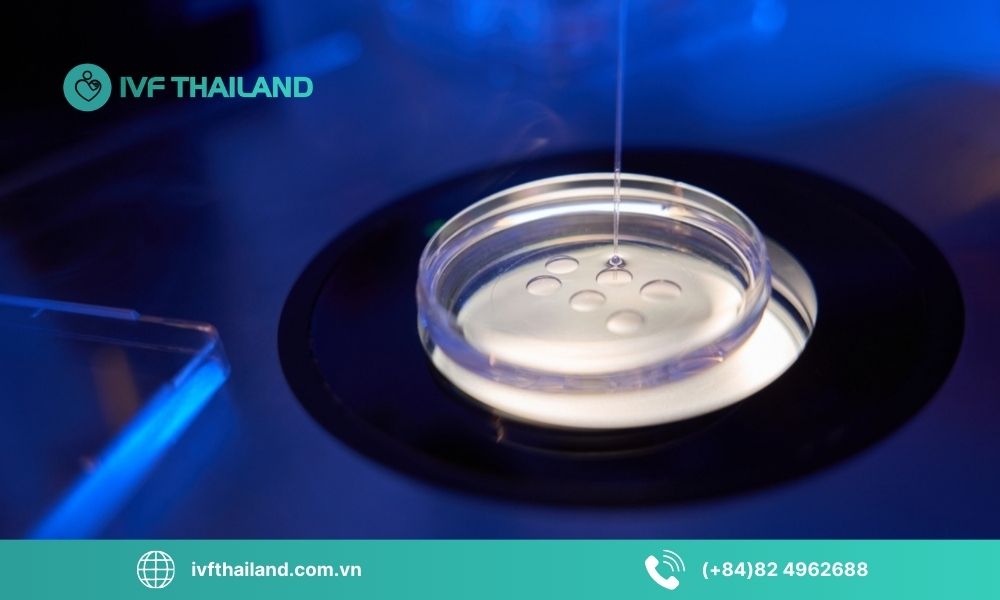
Những yếu tố ảnh hưởng đến chất lượng trứng

Chất lượng trứng đóng vai trò quyết định đến khả năng thụ thai và sự phát triển của phôi thai, nhưng không phải ai cũng hiểu rõ liệu yếu tố này có thể cải thiện không. Ở bài viết này, IVF ThaiLand sẽ phân tích những yếu tố ảnh hưởng trực tiếp đến chất lượng để bạn chủ động bảo vệ sức khỏe sinh sản.
1. Chất lượng trứng là gì?
Chất lượng trứng là yếu tố cốt lõi quyết định khả năng thụ thai và sự phát triển khỏe mạnh của phôi thai. Hiểu đúng khái niệm và vai trò của chất lượng trứng sẽ giúp phụ nữ chủ động hơn trong việc chăm sóc sức khỏe sinh sản và nâng cao cơ hội làm mẹ.
1.1 Khái niệm chất lượng trứng
Chất lượng trứng là thuật ngữ dùng để đánh giá mức độ khỏe mạnh và khả năng phát triển bình thường của trứng. Một trứng được xem là có chất lượng tốt khi:
- Có bộ nhiễm sắc thể bình thường, không sai lệch về số lượng hoặc cấu trúc.
- Có khả năng thụ tinh với tinh trùng và phân chia tế bào ổn định.
- Phát triển thành phôi khỏe mạnh sau khi thụ tinh.
Chất lượng trứng đóng vai trò then chốt trong quá trình thụ thai. Trứng khỏe mạnh giúp tăng khả năng hình thành phôi bình thường, giảm nguy cơ bất thường di truyền và góp phần đảm bảo thai kỳ phát triển ổn định.
1.2 Vì sao chất lượng trứng quan trọng hơn số lượng?
Nhiều người cho rằng chỉ cần số lượng trứng nhiều là đủ, tuy nhiên trong thực tế, chất lượng trứng mới là yếu tố quyết định:
- Tỷ lệ thụ tinh: Trứng kém chất lượng khó thụ tinh hoặc thụ tinh nhưng không phát triển tiếp.
- Nguy cơ sảy thai: Bất thường nhiễm sắc thể ở trứng là nguyên nhân hàng đầu gây sảy thai sớm.
- Tỷ lệ thành công IVF: Trong thụ tinh ống nghiệm (IVF), trứng chất lượng tốt giúp tăng tỷ lệ tạo phôi tốt và nâng cao khả năng đậu thai.
Vì vậy, thay vì chỉ quan tâm đến dự trữ buồng trứng, phụ nữ trong độ tuổi sinh sản cần chú trọng hơn đến việc bảo vệ và tối ưu chất lượng trứng.
=> Xem thêm: Nghỉ Ngơi Và Vận Động Thế Nào Là Hợp Lý Trong Giai Đoạn Hỗ Trợ Sinh Sản?
Chất lượng trứng là gì?
2. Những yếu tố ảnh hưởng đến chất lượng trứng
Chất lượng trứng không chỉ phụ thuộc vào tuổi tác mà còn chịu tác động bởi nội tiết, lối sống, dinh dưỡng và nhiều yếu tố sức khỏe khác. Dưới đây là những yếu tố quan trọng nhất.
2.1 Tuổi tác (Yếu tố quan trọng nhất)
Tuổi là yếu tố ảnh hưởng mạnh mẽ và không thể đảo ngược đối với chất lượng trứng:
- Sau 30 tuổi, chất lượng trứng bắt đầu suy giảm dần.
- Sau 35 tuổi, tốc độ suy giảm rõ rệt hơn.
- Sau 40 tuổi, nguy cơ bất thường nhiễm sắc thể tăng cao, làm giảm khả năng thụ thai và tăng nguy cơ sảy thai.
2.2 Nội tiết tố
Hệ nội tiết đóng vai trò điều hòa sự phát triển và trưởng thành của trứng. Một số chỉ số quan trọng gồm:
- AMH (Anti-Müllerian Hormone): Phản ánh dự trữ buồng trứng.
- FSH (Follicle-Stimulating Hormone): Kích thích nang trứng phát triển.
- Estrogen: Hỗ trợ quá trình rụng trứng và làm dày nội mạc tử cung.
Sự mất cân bằng nội tiết có thể ảnh hưởng đến cả số lượng và chất lượng trứng.
2.3 Lối sống
Thói quen sinh hoạt hằng ngày tác động trực tiếp đến môi trường phát triển của trứng:
- Thức khuya thường xuyên.
- Căng thẳng kéo dài.
- Hút thuốc lá, sử dụng rượu bia.
- Ít vận động.
Những yếu tố này làm gia tăng stress oxy hóa, đây chính là nguyên nhân gây tổn thương tế bào trứng.
2.4 Dinh dưỡng
Thiếu hụt vi chất cần thiết có thể làm suy giảm chất lượng trứng:
- Thiếu omega-3.
- Thiếu vitamin D.
- Thiếu CoQ10.
- Thiếu sắt, kẽm và các chất chống oxy hóa.
Chế độ ăn thiếu cân đối lâu dài sẽ ảnh hưởng đến chức năng buồng trứng.
2.5 Cân nặng
Cân nặng không hợp lý làm rối loạn nội tiết:
- Thừa cân, béo phì gây kháng insulin và rối loạn rụng trứng.
- Suy dinh dưỡng khiến cơ thể thiếu năng lượng để duy trì hoạt động sinh sản bình thường.
Duy trì BMI ổn định giúp tối ưu môi trường nội tiết.
2.6 Bệnh lý phụ khoa và toàn thân
Một số bệnh lý có thể ảnh hưởng trực tiếp hoặc gián tiếp đến chất lượng trứng:
- Hội chứng buồng trứng đa nang (PCOS).
- Lạc nội mạc tử cung.
- Viêm nhiễm phụ khoa kéo dài.
- Bệnh tuyến giáp.
- Tiểu đường.
Việc kiểm soát tốt các bệnh nền giúp hạn chế tổn thương buồng trứng.
2.7 Yếu tố môi trường
Môi trường sống hiện đại cũng là yếu tố cần lưu ý:
- Ô nhiễm không khí.
- Tiếp xúc hóa chất độc hại.
- Nhựa chứa BPA và các chất gây rối loạn nội tiết.
Giảm tiếp xúc với các tác nhân này góp phần bảo vệ sức khỏe sinh sản lâu dài.
Những yếu tố ảnh hưởng đến chất lượng trứng
3. Cách cải thiện chất lượng trứng theo khuyến nghị chuyên gia
Dù không thể đảo ngược quá trình lão hóa buồng trứng, phụ nữ vẫn có thể cải thiện môi trường phát triển của trứng thông qua lối sống khoa học, dinh dưỡng hợp lý và theo dõi y tế đúng cách.
3.1 Điều chỉnh lối sống
Lối sống là yếu tố có thể tác động tích cực đến chất lượng trứng nếu được điều chỉnh kịp thời:
- Ngủ trước 23h: Giấc ngủ sâu và đủ giúp cân bằng nội tiết, đặc biệt là hormone sinh sản.
- Tập thể dục vừa phải: Duy trì 30 phút vận động mỗi ngày giúp tăng tuần hoàn máu đến buồng trứng.
- Giảm stress: Thiền, yoga hoặc các hoạt động thư giãn giúp hạn chế stress oxy hóa.
3.2 Bổ sung dinh dưỡng hỗ trợ trứng khỏe
Một số vi chất được chứng minh có lợi cho sức khỏe buồng trứng:
- CoQ10: Hỗ trợ chức năng ty thể và cải thiện năng lượng tế bào trứng.
- Omega-3: Giảm viêm và hỗ trợ cân bằng nội tiết.
- Vitamin D: Liên quan đến chức năng sinh sản và chất lượng trứng.
- Acid folic: Hỗ trợ quá trình phân chia tế bào và giảm nguy cơ bất thường nhiễm sắc thể.
- Chế độ ăn Địa Trung Hải: Giàu rau xanh, cá béo, dầu olive và hạt dinh dưỡng sẽ giúp tăng chất chống oxy hóa tự nhiên.
Việc bổ sung nên có sự tư vấn của bác sĩ để phù hợp với từng tình trạng cụ thể.
3.3 Theo dõi sức khỏe sinh sản định kỳ
Chủ động kiểm tra giúp phát hiện sớm dấu hiệu suy giảm chức năng buồng trứng:
- Xét nghiệm AMH: Đánh giá dự trữ buồng trứng.
- Siêu âm nang noãn: Theo dõi sự phát triển của nang trứng.
- Tư vấn bác sĩ sản phụ khoa: Được hướng dẫn cá nhân hóa kế hoạch chăm sóc sinh sản.
Kiểm tra định kỳ giúp tối ưu thời điểm mang thai và có phương án can thiệp sớm nếu cần.
3.4 Can thiệp y khoa khi cần thiết
Trong một số trường hợp, can thiệp chuyên sâu có thể được chỉ định:
- Kích trứng: Hỗ trợ phát triển nhiều nang trứng trong chu kỳ điều trị.
- IVF (thụ tinh trong ống nghiệm): Tăng cơ hội thụ thai khi chất lượng trứng suy giảm.
- Đông lạnh trứng: Bảo tồn khả năng sinh sản ở độ tuổi còn thuận lợi.
Việc lựa chọn phương pháp nào cần dựa trên đánh giá toàn diện của bác sĩ chuyên khoa hiếm muộn.
=> Xem thêm: Những Sai Lầm Phổ Biến Khi Các Cặp Đôi Lần Đầu Lên Kế Hoạch Có Con
Cách cải thiện chất lượng trứng theo khuyến nghị chuyên gia
4. IVF ThaiLand – Trung tâm hỗ trợ sinh sản chất lượng, uy tín, an toàn tuyệt đối
Nếu bạn đang gặp khó khăn trong việc thụ thai tự nhiên, từng thất bại với các phương pháp điều trị trước đó hoặc lo lắng về chất lượng trứng suy giảm theo tuổi tác, thì việc tìm đến một trung tâm hỗ trợ sinh sản chuyên sâu như IVF ThaiLand có thể là bước đi quan trọng giúp bạn rút ngắn hành trình tìm con và gia tăng cơ hội làm cha mẹ một cách an toàn, hiệu quả. Chúng tôi cam kết:
- Tư vấn minh bạch, cá nhân hóa phác đồ điều trị theo từng tình trạng cụ thể.
- Ứng dụng công nghệ hỗ trợ sinh sản tiên tiến, đảm bảo tiêu chuẩn an toàn nghiêm ngặt.
- Theo dõi sát sao trong suốt quá trình điều trị, tối ưu tỷ lệ thành công.
- Bảo mật tuyệt đối thông tin khách hàng.
- Đồng hành tận tâm, hỗ trợ toàn diện từ tư vấn ban đầu đến khi đạt được kết quả mong đợi.
Hãy liên hệ với chúng tôi ngay hôm nay để được tư vấn chuyên sâu và xây dựng lộ trình điều trị phù hợp, gia tăng cơ hội chạm tay vào hạnh phúc làm cha mẹ của bạn.
Xem thêm dịch vụ tại IVF ThaiLand:
THÔNG TIN LIÊN HỆ
IVF THAILAND
Hotline Vietnam: (+84)82 4962688
Hotline Thailand: (+66)924 979 928
Email: daisyvu6565@gmail.com
Website: ivfthailand.com.vn
Fanpage: IVF Thailand – TTON Tại Thái Lan & IVF tại Thái Lan